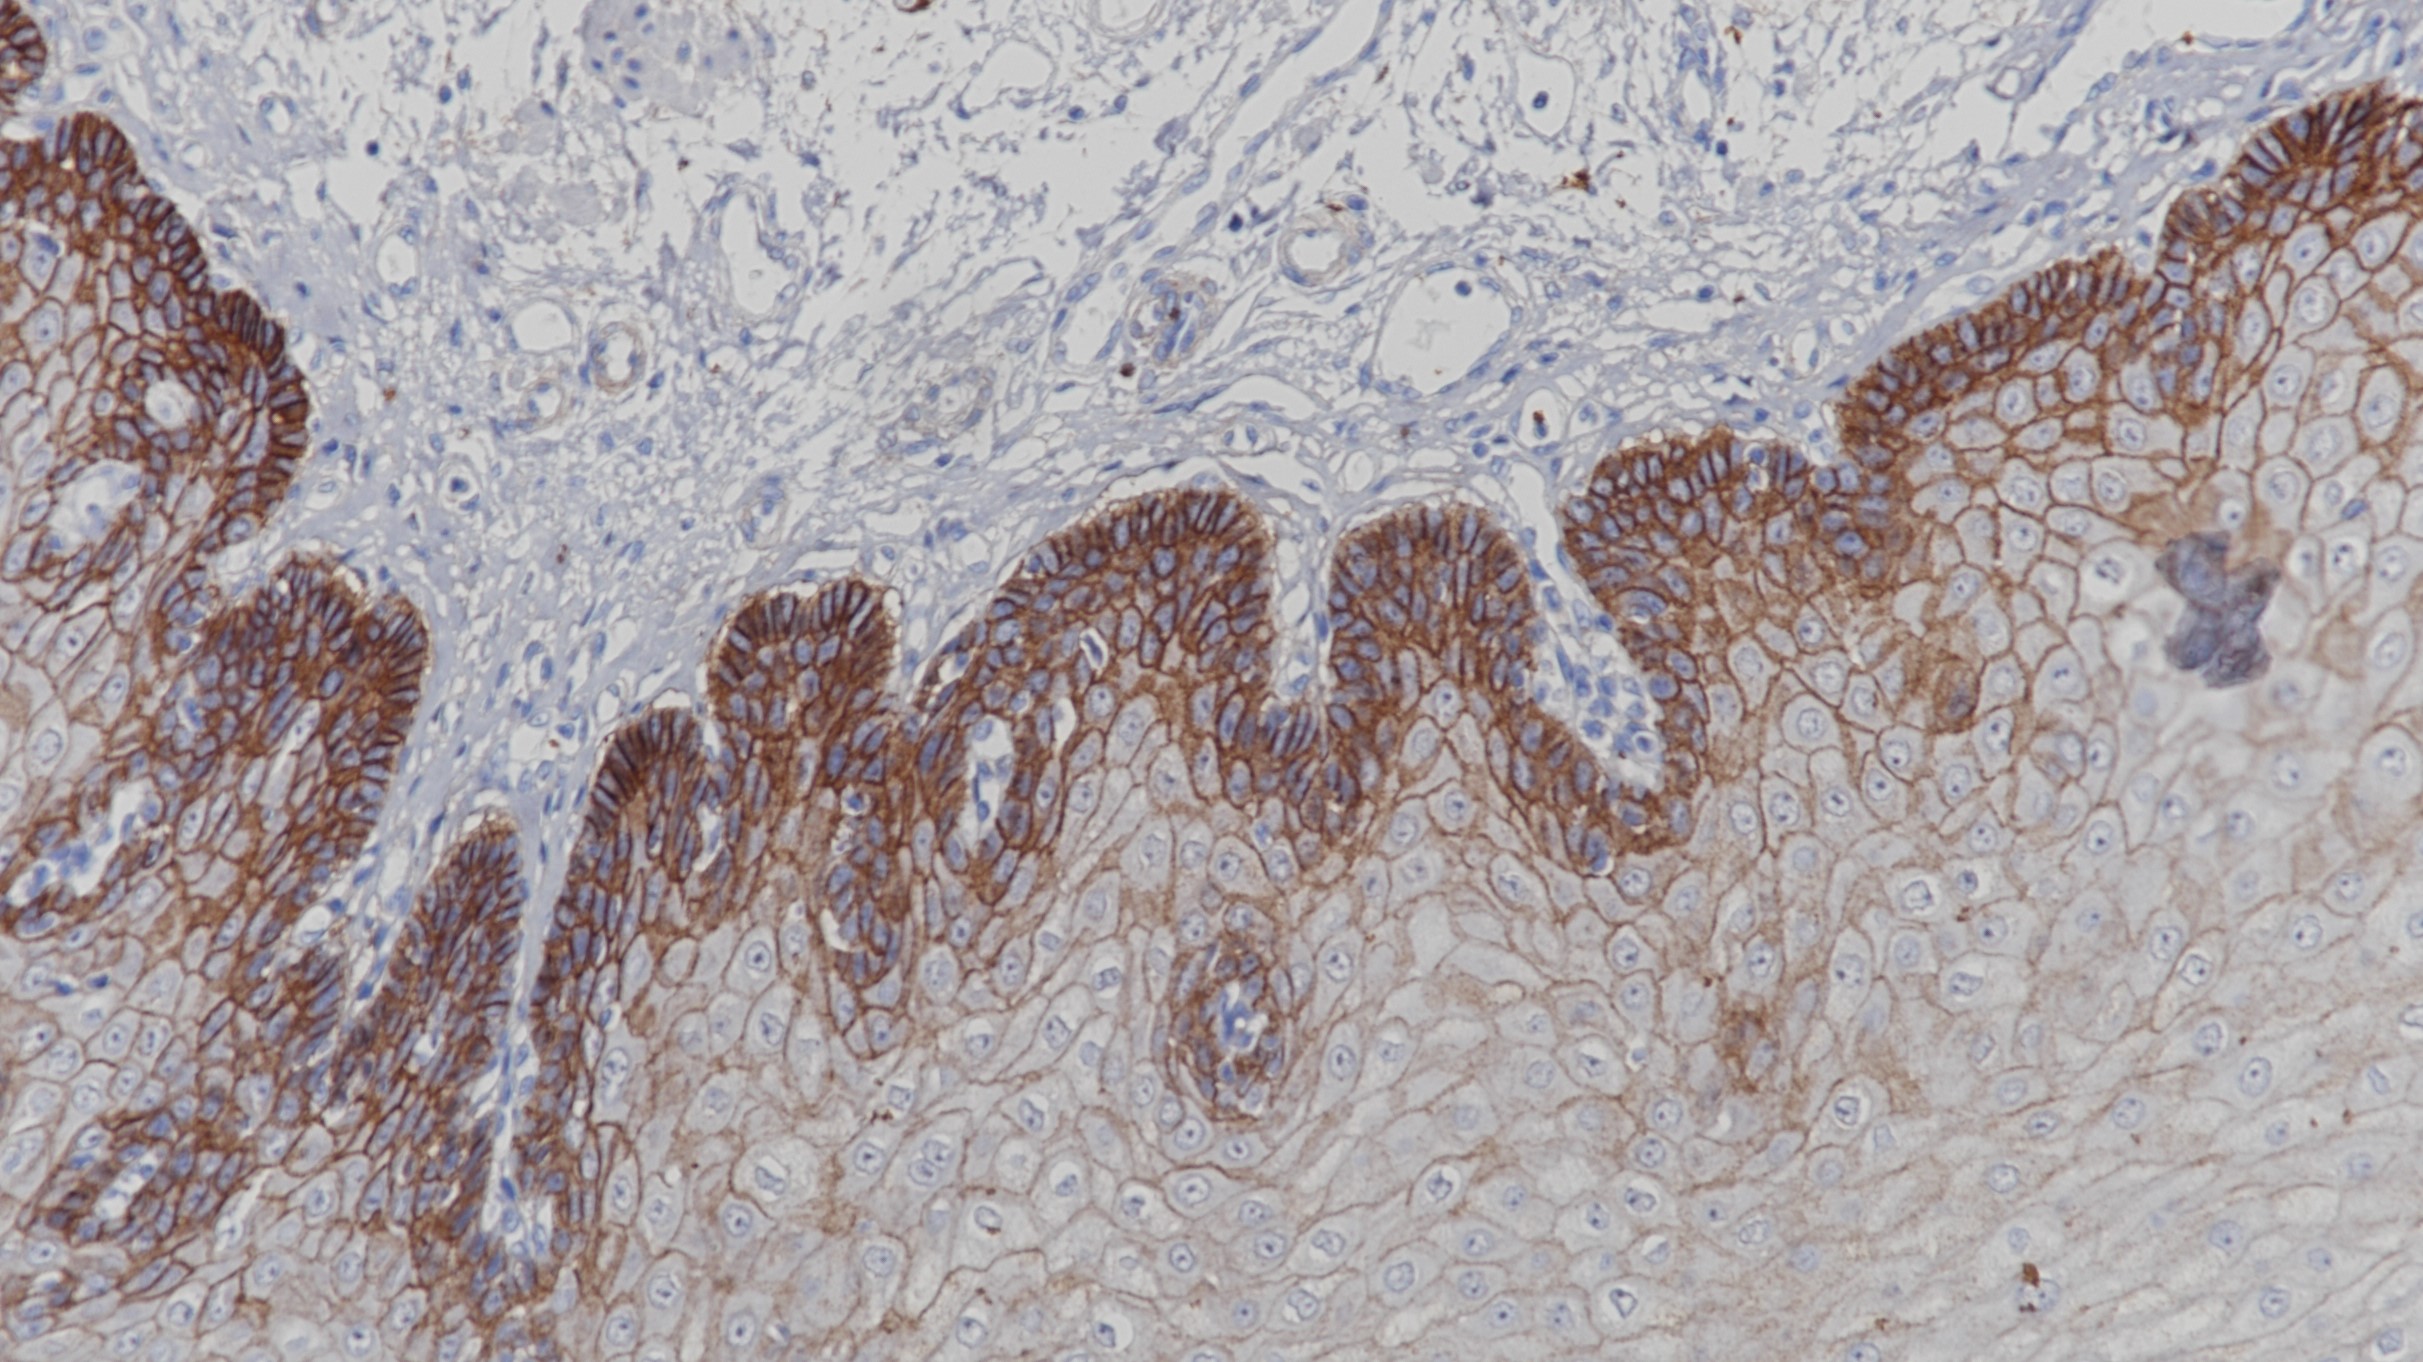
食管EGFR(BP6097)染色

1. Zhu C Q, Da C S G, Ding K, et al. Role of KRAS and EGFR as biomarkers of response to erlotinib in National Cancer Institute of Canada Clinical Trials Group Study BR.21.[J]. Journal of Clinical Oncology, 2008, 26(26):4268-4275.
2. Ciardiello F, Tortora G. Epidermal growth factor receptor (EGFR) as a target in cancer therapy: understanding the role of receptor expression and other molecular determinants that could influence the response to anti-EGFR drugs.[J]. European Journal of Cancer, 2003, 39(10):1348-1354.
3.中华医学会.《临床技术操作规范·病理学分册》.人民军医出版社,2004.